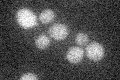
YBR022W
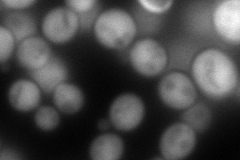
YBR022W
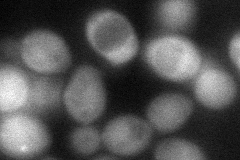
YBR022W
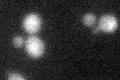
YBR022W
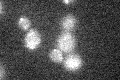
YBR022W

View description
Phosphatase that is highly specific for ADP-ribose 1''-phosphate, a tRNA splicing metabolite; may have a role in regulation of tRNA splicing
Localization:
Intensity:
Fold change:
Significance:
-
C’ GFP library in SD
below threshold18.93 -
N' NOP1pr-GFP in SD

below threshold0 -
N' TEF2pr-mCherry in SD
cytosol200.445 -
N' NATIVEpr-GFP in SD

cytosol37.0093 -
N' TEF2pr-VC and Cyto-VN in SD
cytosol63.7442 -
C’ GFP library in SD+DTT
cytosol14.10.74No -
C’ GFP library in SD+H2O2
cytosol16.830.88No -
C’ GFP library in Starvation Media

cytosol16.440.86No -
C’ GFP library on the background of Pup2-DaMP

below threshold -
C’ GFP library on the background of CCT mutant

below threshold17.34860.916306No
